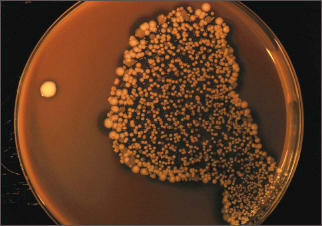

Research Review
Hand Washing and Contact Lens Contamination

By Loretta B. Szczotka-Flynn, OD, PhD, MS, FAAO
We all tell our patients to wash their hands before handling contact lenses. What is the evidence to support this recommendation? You may be surprised when you see what the published studies reveal. The most relevant study in the contact lens field was published by Ly et al in 1997. They asked 47 subjects to perform five different hand-washing procedures and then handle a new, sterile contact lens. The contact lenses were then cultured to determine the number of colony forming units (CFUs) on the lenses.
In short, they found that ordinary hand washing did not decrease, and in fact increased the amount of contaminants transferred from the hands to a hydrogel contact lens. I surveyed the literature to see what other papers have been published on this topic and to shed some light on the rationale for this paradoxical finding.
Indeed, there are several published studies that have found this same effect; specifically, there is typically an increase in bacterial counts on skin after hand washing with plain soap and water (Larson, 1986; Meers, 1978; Winnefeld, 2000). Additionally, among 224 healthy homemakers, a single hand wash had little to no impact on microbial counts (Larson, 2002).
These studies assessed nonmedicated soaps and alterations to normal skin flora only.
Figure 1. A large number of CFU of coagulase negative staphylococci extracted from a never worn daily disposable lens that was handled for about 30 seconds with washed hands.
Should Lens Wearers Be Concerned about Skin Flora?
Skin flora is typically determined to be either resident or transient. Resident flora consists of permanent inhabitants of the skin that are found mainly on the skin's surface and under the superficial cells of the statum corneum (Kampf, 2004). These resident bacteria are known to be protective in that they are antagonists to other bacterial invasion as they compete for nutrients. Thus resident flora survive on the skin longer than transient species do. The dominant resident species is Staphylococcus epidermidis, which is found on almost every hand (Kampf, 2004). The resident flora are not considered to be pathogenic on the intact skin, but they can cause infections in sterile body cavities, on non-intact skin, or the in eyes (Kampf, 2004; Lark, 2001).
Normal skin flora can be found in very high amounts after washed or unwashed hands handle inanimate surfaces such as contact lenses. In Ly's study, thousands of CFUs were recovered from the handled contact lenses (Ly, 1997). However, the eye is tremendously capable of removing such flora from lenses during wear. In one study patient-handled lenses were 100-percent contaminated with bacteria with a median of 653 CFU/lens of viable microorganisms. These same patients handled the lenses and then wore them for five hours. After this short-term wear, fewer than half of the lenses exhibited bacteria and the median bacterial count was only 30 CFU/lens (Mowry-McKee, 1992).
Nonetheless, studies have shown that S. epidermidis and other coagulase negative staphylococci are still associated with contact lens-related corneal infection and inflammation (Szczotka-Flynn, 2010; Catalanotti, 2005; Tabbara, 2000).
Transient and Pathogenic Flora
Transient skin flora consist of many bacteria, fungi, and viruses that are present occasionally and usually don't multiply on the skin, but yet they survive, can be transmitted, and cause disease (Kempf, 2004). Of interest to contact lens practitioners, Pseudomonas spp. can be found on 1.3 percent to 25 percent of healthcare workers' hands, which can persist up to 180 minutes on the hands and up to 16 months on inanimate surfaces (Kempf, 2004).
The good news is, hand washing with non-medicated soap and water is effective in reducing transient hand flora when using established models of artificially contaminated hands. For example, a 30-second hand wash has been shown to reduce levels of P. aeruginosa by two to three logs (Kempf, 2004). The hand wash simply removes the loosely adherent microorganisms from the hands by mechanical action.
Medicated Soaps
Just as plain soap and water were ineffective at reducing resident skin flora, antimicrobial soaps are similarly ineffective at removing resident hand flora (Kempf, 2004). However, in artificially contaminated hand models, antimicrobial soaps were shown to be more effective compared to their non-antimicrobial counterparts in reducing the levels of introduced pathogens (Fuls, 2008).
Additionally, bacterial reductions with antimicrobial soaps are significantly improved by longer wash times and greater soap volumes (Fuls, 2008).
One the most popular agents found in antimicrobial soaps for the reduction of numbers of pathogens from hands is Triclosan (Figure 2). This agent was introduced in 1965 under many marketed names. Triclosan is effective against gram positive bacteria, more effective on gram positive than gram negative bacteria, and effective against fungi and MRSA (Kampf, 2004). Triclosan's mechanism of action is known (blocks lipid synthesis), and there are concerns that bacterial resistance to Triclosan is occurring through the evasion of such mechanisms (Kampf 2004). Of relevance to us, certain Pseudomonas species are not susceptible and/or are resistant to Triclosan.

Figure 2. Hospital grade antimicrobial soap showing the active ingredient is Triclosan.
The FDA issued a consumer update on Triclosan in April 2010 (www.fda.gov/downloads/ForConsumers/ConsumerUpdates/UCM206222.pdf.). The update states that there are recent concerns of altered hormonal regulation secondary to use of Triclosan in animal studies. Nonetheless, the agent is not known to be hazardous to humans, and the FDA does not have sufficient safety evidence to recommend changing consumer use of Triclosan-containing products at this time.
What Does This Mean to Contact Lens Wearers?
The greatest concern of practitioners fitting contact lenses remains infection with pathogenic organisms. Therefore, to prevent the transfer of pathogens from hands to lenses during the application and removal process, washing hands with an antimicrobial soap is advocated.
Additionally, washing hands for a total of 30 seconds using two pumps of foaming soap is more efficacious than is a 15-second wash with one pump (Fuls, 2008).
Little effect is achieved on the reduction of resident flora with typical hand-washing procedures. Therefore, infectious or inflammatory contact lens complications related to resident hand flora are still probable, even in patients who claim compliance with these procedures. CLS
For references, please visit www.clspectrum.com/references.asp and click on document #186.
Dr. Szczotka-Flynn is an associate professor at the Case Western Reserve University Dept. of Ophthalmology & Visual Sciences and is director of the Contact Lens Service at University Hospitals Case Medical Center. She has received research funding from Ciba, Vistakon, Alcon, and CooperVision. You can reach her at loretta.szczotka@UHhospitals.org.



